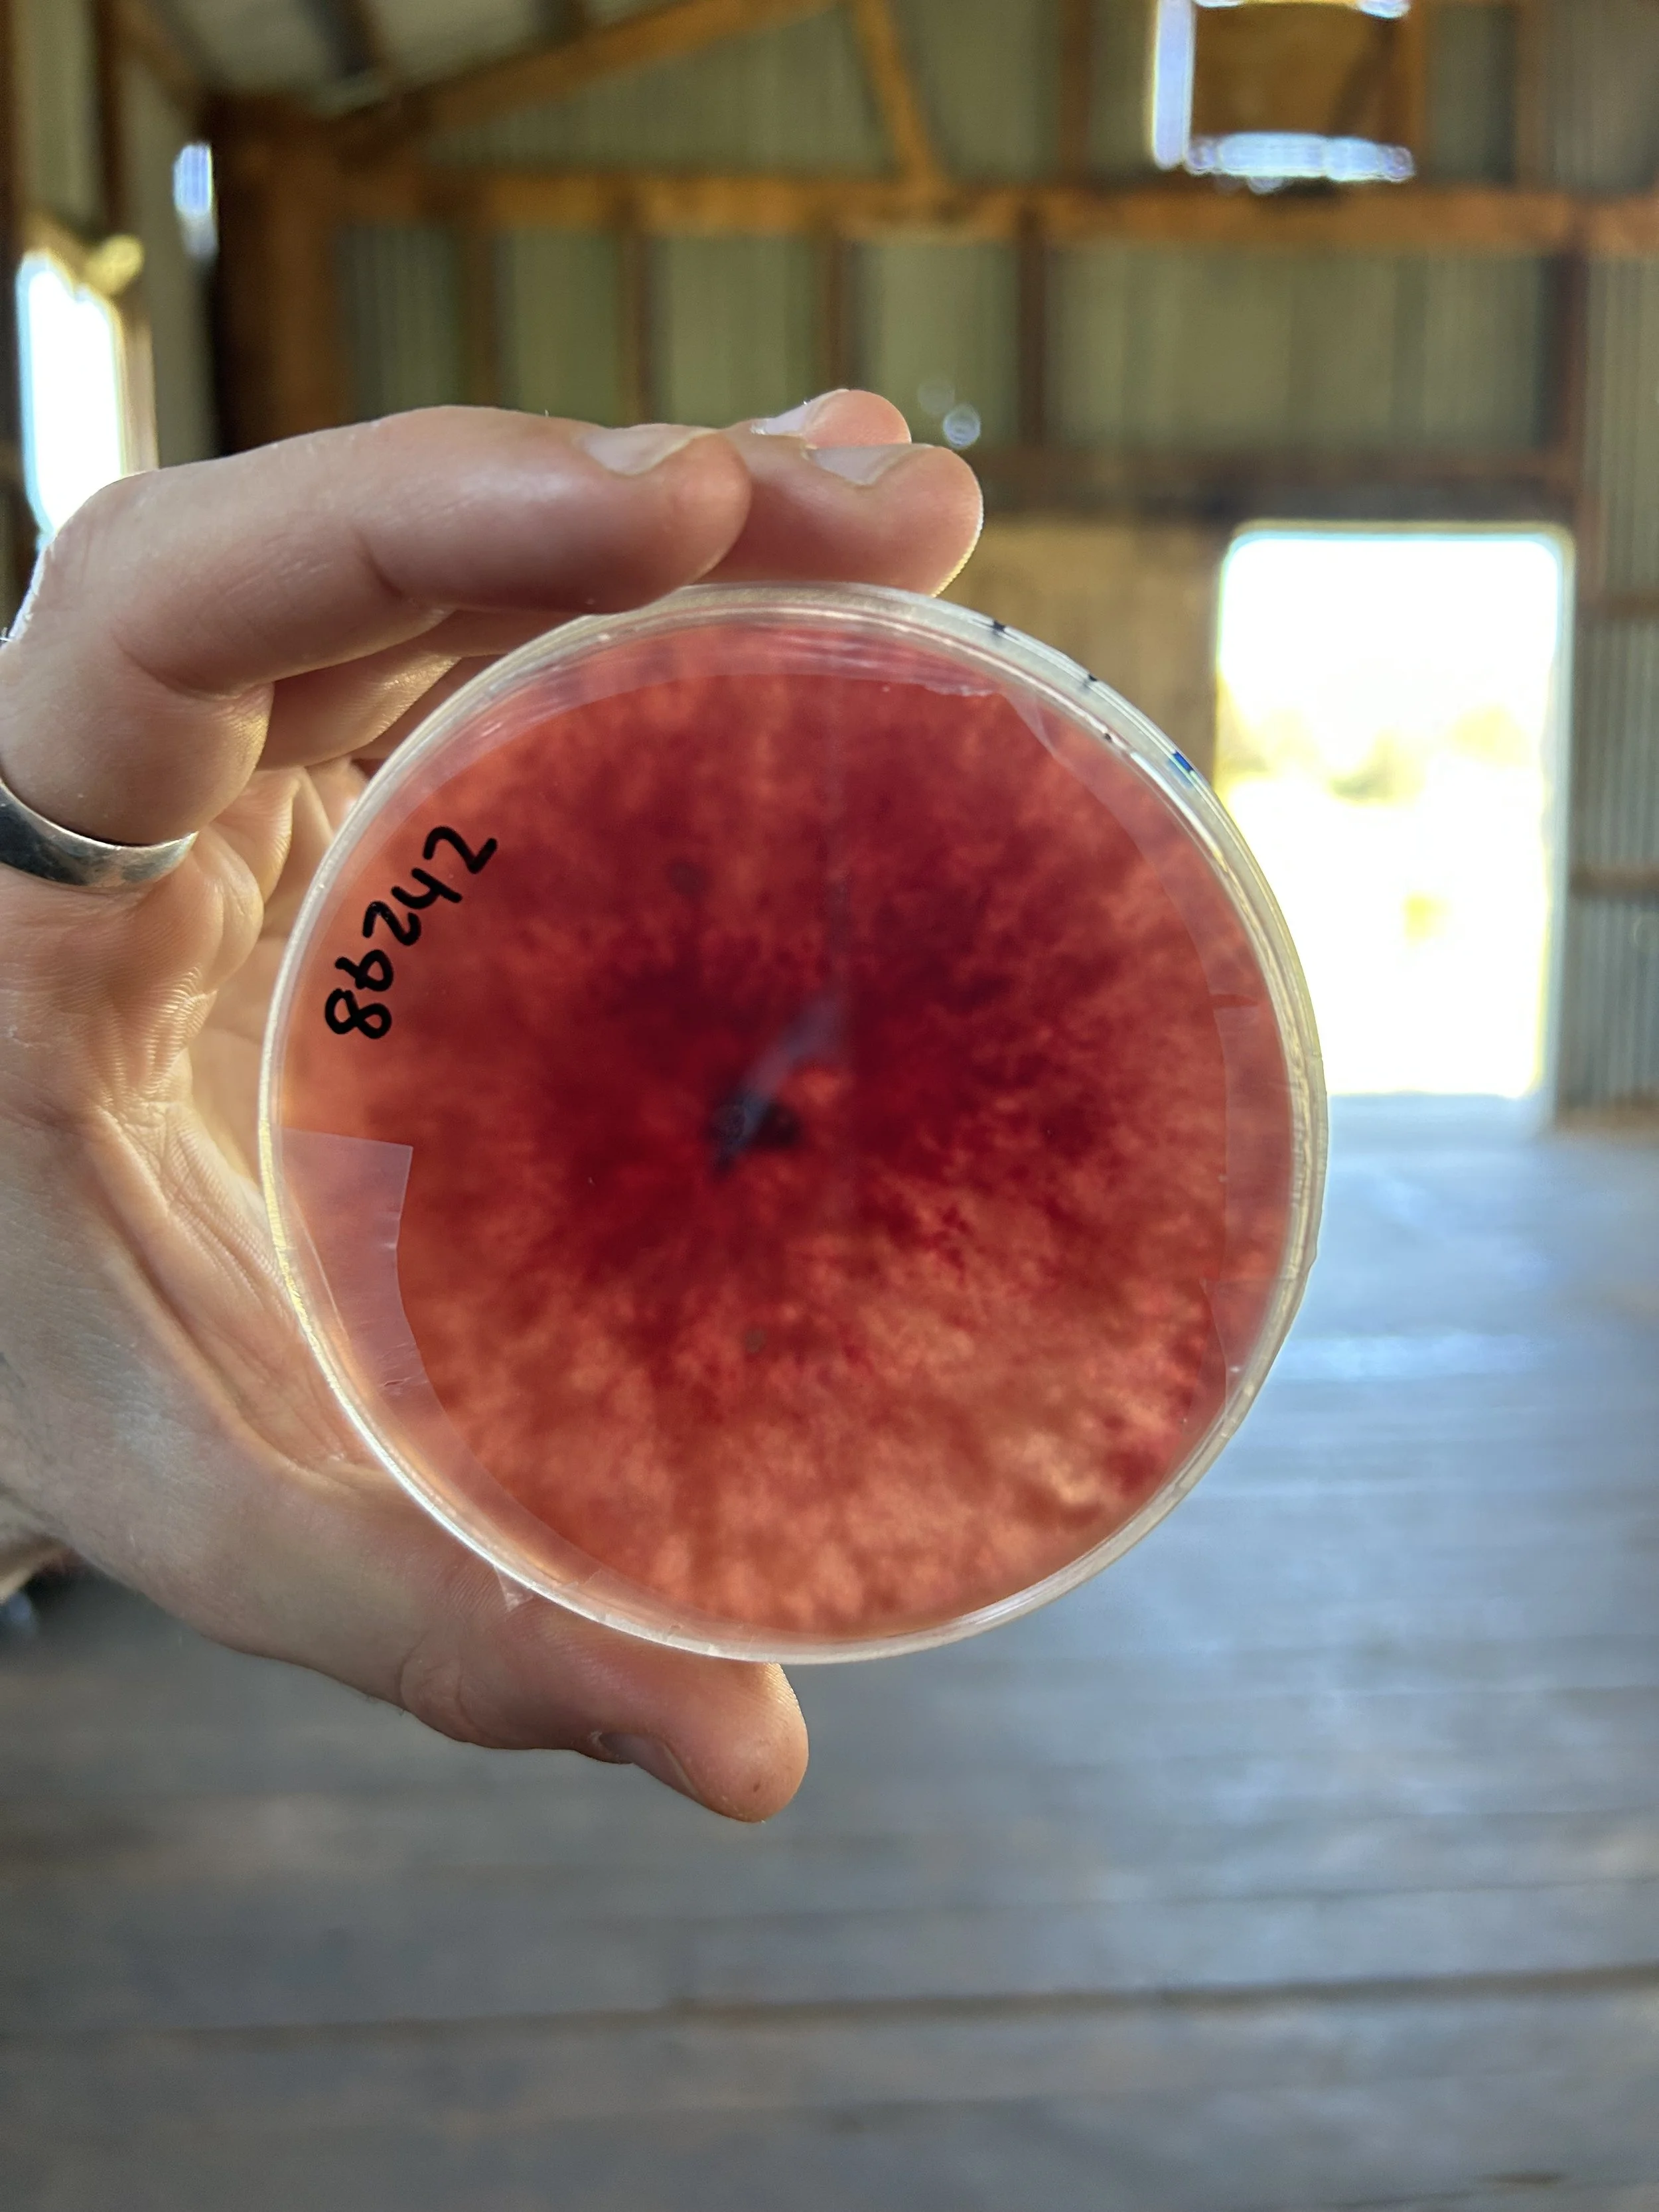
IMG_5191.jpeg

Cowra Orange Cabonne Science Hub convened by The Corridor Project
Our year round community science workshops aim is to stimulate, educate and bring awareness to STEAM [science technology engineering arts maths] for communities and youth. Over the past decade our Science Hub delivered through The Corridor Project has delivered over 100+ workshops and events to communities living in NSW. The year round workshops and National Science week is supported by Inspiring Australia NSW and partnering organisations, read further about the Regional NSW Science Hubs HERE.
Steven Cavanagh and Dr Jordan Bailey workshop
Orange Cowra Cabonne Science Hub - Supported by Inspiring Australia
Have you ever wondered what makes fungi blue? Discover the extraordinary scientific world through nature based learning. Join us for a day of field walks and talks in learning how to make Cyanotypes and a deep dive into the world of fungi and pathogens.
Join us for the day with Dr Jordan Bailey, discussing fungi and plants followed by Photo-media artist Steven Cavanagh who will facilitate a workshop processing Cyanotypes and sculptural constructions using organic material collected from site [all materials provided]
NOTE: this is an excellent opportunity to make prints and sculptures for family and friends!!
Tutors: Steven Cavanagh is a photomedia artist, educator, curator who currently works at the National Art School Sydney and Arts Out West NSW. Steven has previously collaborated with The Corridor Project and Orange Cowra Cabonne Science Hub as an artist and educator. Dr Jordan Bailey is the Institute Director and Leader Plant Pathology Curation | Plant Biosecurity Research and Development at the Department of Primary Industries Orange.
Image credit above: Steven Cavanagh producing new work at The Corridor Project for the Orange Regional Gallery ‘Material Measure’ Exhibition 2022.
Sydney based architectural - arts - cultural company, Cave Urban will present a x2 day workshop teaching methodologies in how to build a structure from Invasive species onsite.
Join our STEAM Hub for a two day workshop with celebrated arts, architecture and cultural company Cave Urban. The two day workshop will bring together local communities and artists/architects collaborating in the construction of a dome dwelling, using traditional weaving techniques and construction methodologies. The constructions will be publicly exhibited as a site ‘environment’ installation for inaugural event ERTHWRX24 during National Science Week August 2024, located at the CORRIDOR project [All materials provided]
Presenters: Cave Urban Tutor: Juan-Pablo - Co-Founder | Creative Director CAVE URBAN
Chilean architect and sculptor Juan Pablo was born in Santiago in 1978. He studied Architecture at the University of Chile and holds a Masters in Sustainable Design from The University of Sydney, founded by the Chilean Government through the Becas Chile Scholarship program. Co-Founder of international collective Cave Urban, he started carrying out research in bamboo structures and vernacular architecture in 2011. Pablo participated in a series of bamboo workshops and cross-cultural exchanges in Thailand, Taiwan and Portugal. Throughout his career Pablo has had a close involvement with large scale installations and public sculpture. His work encompasses a wide spectrum of materials; from the traditional - steel and bronze, to the ephemeral - bamboo, ice and snow. He has represented Chile in several snow and ice sculpting competitions around the world including competitions held in China, Japan, Argentina and Canada.
Producers: The Corridor Project & facilitated by Orange Cowra Cabonne Science Hub - Supported by Inspiring Australia
Image credit above: CAVE URBAN - Transience | Sculpture by the Sea, Bondi 2019.
Chromatograms, soil and tree health workshop - 2023
What a sparkling day with community learning about soil and tree health through an all-day program of talks, field-walks and chromatogram making. This workshop focussed on soil and tree health on site at the CORRIDOR project whilst using the chromatogram process as a tool for scientific exploration and artist expression. Our STEAM HUB called the Cowra Orange Cabonne Science Hub has programmed year round workshops and National Science Week events for over 10 years delivering over 80+ science arts experiences to communities, artists and youth.
On Sunday 17 September we were joined by Dr Jordan Bailey, Leader of Plant Pathology Curation, Biosecurity Collections at the local Orange Department of Primary Industries office, who lead us through a fascinating presentation about fungi and their role in plant and soil health, as decomposers, antagonists, and symbionts, and how humans are harnessing their powers to heal our ecosystems and reduce our carbon footprint.
Artist Sammy Hawker then led the group on a field study collecting samples from fallen leaves, soil, shred bark, moss and fungus from local endemic trees sited on the property. The collected samples were then used to create a chromatograms, adapting the laboratory technique used to separate a mixture into its components, most often used in chemistry. For Sammy, using the technique of chromatography facilitates the visual expression of vibrant matter, and the result can be understood as a self-portrait of the tree. The chromatograms in collaboration with community and Sammy will be exhibited as part of ERTHWRX for National Science Week 2024. Supported by Inspiring Australia and the CORRIDOR project. Article by Chair of Inspiring Australia Emily Jateff HERE
TESTIMONIALS
“One hundred percent worth the drive from Sydney to attend the recent Chromatograms, Soil and Tree Health Workshop. A perfect blend of art and science, we were wowed by Dr Jordan Bailey’s deep knowledge of fungi (and sprightly delivery of fun facts and things to touch!) after which Sammy brought us back to nature with a directive to wander the gorgeous grounds and silently collect samples that spoke to us of trees and soil. After a lovely lunch, we gathered again in the impressive woolshed studio space to blend and shake our collected samples for infusion into stunning chromatographs. I cannot recommend The CORRIDOR project highly enough and suggest to anyone up for visit that they take advantage of the stunning, environmentally sympathetic and sustainable surroundings to spend the night, relax, immerse yourselves in the landscape and return to earth. Very well done to all!”
“In September 2023 I facilitated a workshop where participants were asked to collect a small sample from a tree onsite at the CORRIDOR project and together we created a chromatogram. The workshop followed a riveting presentation from Dr Jordan Bailey who talked about & passed around fascinating fungi specimens. This was a great precursor to my workshop as it inspired participants to expand their thinking of a tree to the symbiotic relationship between trees and the mycelium network that connects them. At the beginning of my workshop I invited everyone to consciously ground using an exercise of deep listening from Pauline Oliveros text ‘Quantum Listening’, before participants ventured off to quietly to collect a small sample. People came back with a variety of materials including tree-sap, skeleton leaves, lichen growing on trees and even cow dung under a kurrajong tree. The result of the chromatograms were vivid and interesting and will be exhibited during the National Science Week 2024 as part of the CORRIDOR project ERTHWRX event”
“The Fungi/Chromatogram workshop at the CORRIDOR project was fantastic! The pairing of Jordans impressive and expansive knowledge with Sammy’s calm and deeply thoughtful artistry made for a wonderful day. The facilitation and support provided by the CORRIDOR project team glued the experience together in what seemed to be effortlessly and yet it was clear how much care and consideration had gone into the day. I came away from the experience enlivened and satisfyingly full of amazing knowledge, creative inspiration and delicious food ”
“Always lovely to be at the CORRIDOR project. Bravo to the two engaging people sharing their insights and projects. Jordan certainly is a pocket rocket and a mine of information…..a true communicator happy to share her knowledge in an engaging and especially fun way. If my voice wasn’t much more than a croak, would have spoken to her afterwards about a recent article in April new scientist about (yeah, creepy esp as I’m not a fan of) how male cockroaches are evolving to avoid modern baits. Not a fungi based topic however an interesting case of adaptation to modern household chemical warfare. Sammy is a gem. Passionate, energetic and kind. Guiding the group meditation prior to the sample collection for the chromatogram project was apt .. to be calm, quiet and cantered. The interesting premise and research being that the ‘frame of mind’ could/would influence the image making process for chromatogram image”
“I always enjoy the gathering of people. There were new faces and conversations shared over the course of the day. Dr Jordan Bailey spoke passionately about the NSW Herbarium giving fascinating insights into the history of the collection. Sammys deep knowledge in this area of science was enhanced with stories of how it has been applied to unexpected projects and investigations. Sammy Hawkers workshop successfully made me feel I was moving between science and artmaking. The two fused perfectly. I’ve always enjoyed the magic in photography and scientific experiments. Sammy’s workshop exposed a magic and experience, unique to each of us. Even though some of my romantic notions of a herbarium were dashed I came away knowing something new and a closer connection to the environment. Well done everyone”
“Thank you for a great day at a recent workshop at the CORRIDOR project. Such a beautiful place to spend our day. It was a fantastic combination of learning things about the natural world, in this case from Jordan with her extensive knowledge and experience working with fungi, and then the opportunity to make chromatograms with Sammy. My daughter and I learnt so much from both parts of the workshop. We thoroughly enjoyed our day - a great combination of learning and creating. Thank you Jordan, Sammy, Phoebe and Dylan. We look forward to attending future workshops”
“I felt very lucky to be a participant at the 2023 Science Week First Nations science event at the CORRIDOR project, especially as we were fortunate to have such brilliant presenters sharing their knowledge and experiences with us. The weekend was challenging and illuminating and I learnt so much. Aleisha Lonsdale gave us the most insightful and incisive experiences of First Nation scientific and cultural methodologies and practices. Aunty Esther Cutmore’s natural river history and revealing social practices discussion and tour were so impactful. The accommodation, meals and facilities were absolutely amazing, inspiring and so generous. Thanks so much to the TCP team and absolutely everyone else involved in the organisation and sharing of the event as well as the warm and gorgeous people we were lucky enough to have in the group on the weekend”
“What a fascinating workshop! From Jordan’s informative talk with amazing examples of fungi to Sammy’s meditative inspiration from our field walk and collection of natural materials. I had a fun and creative day and look forward to seeing the final results of the Chromatograms.Thank you.”